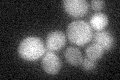
YPR158W
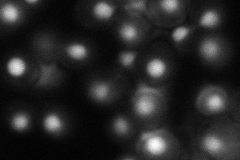
YPR158W
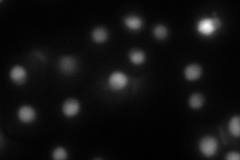
YPR158W

View description
Protein of unknown function involved in destabilization of [URE3] prions; similar in sequence to Btn2p
Localization:
Intensity:
Fold change:
Significance:
-
C’ GFP library in SD
below threshold16.43 -
N' NOP1pr-GFP in SD
nucleus77.5204 -
N' TEF2pr-mCherry in SD
nucleus70.4633 -
N' NATIVEpr-GFP in SD

nucleus35.1725 -
N' TEF2pr-VC and Cyto-VN in SD

nucleus35.8542 -
C’ GFP library in SD+DTT

cytosol16.390.99No -
C’ GFP library in SD+H2O2

cytosol16.090.97No -
C’ GFP library in Starvation Media

cytosol13.590.82No -
C’ GFP library on the background of Pup2-DaMP

below threshold -
C’ GFP library on the background of CCT mutant

below threshold17.67111.07519No
